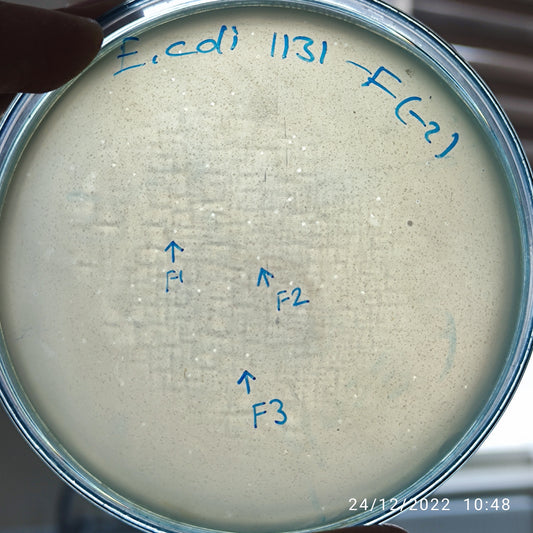
Escherichia coli bacteriophage 101131F
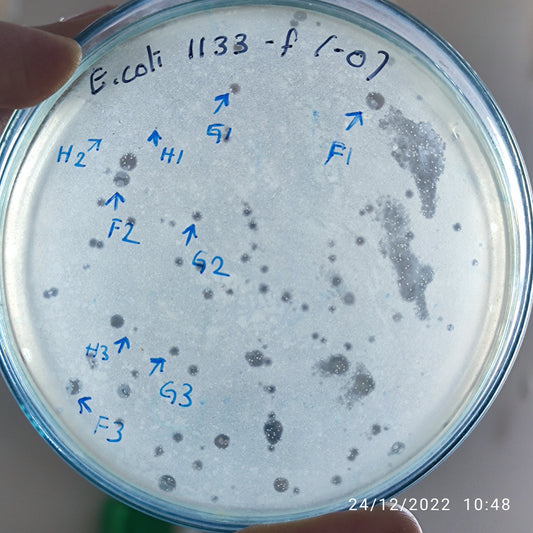
Escherichia coli bacteriophage 101133G
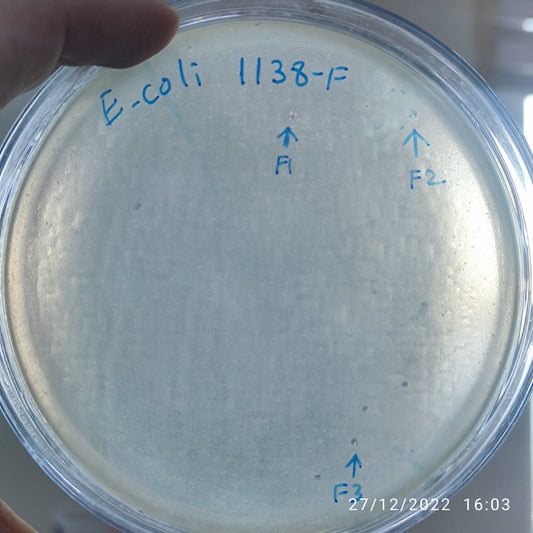
Escherichia coli bacteriophage 101138F
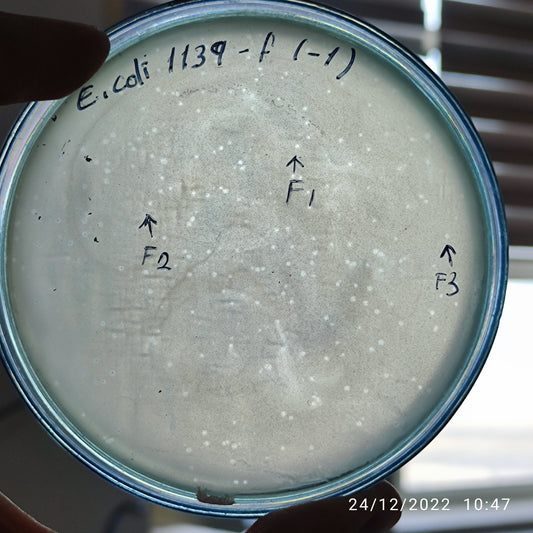
Escherichia coli bacteriophage 101139F
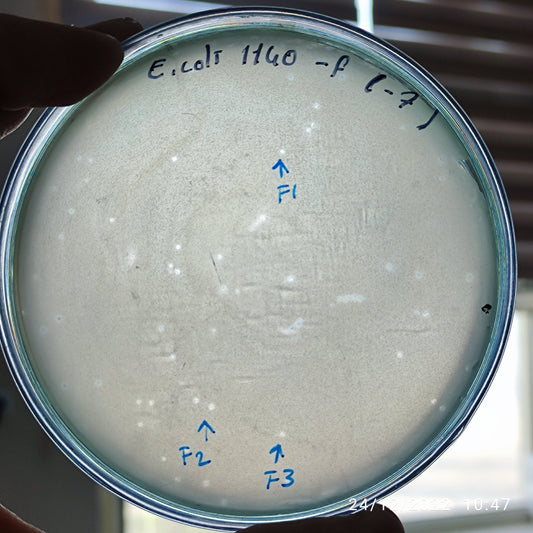
Escherichia coli bacteriophage 101140F
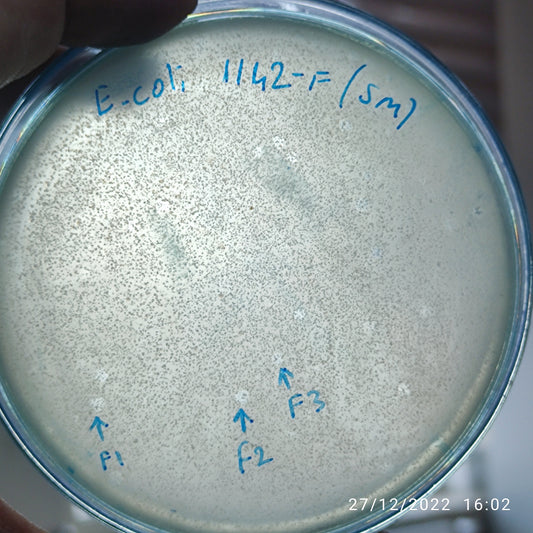
Escherichia coli bacteriophage 101142F
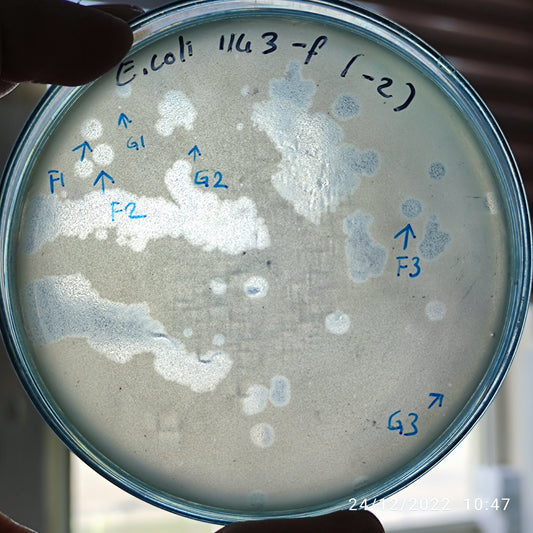
Escherichia coli bacteriophage 101143F
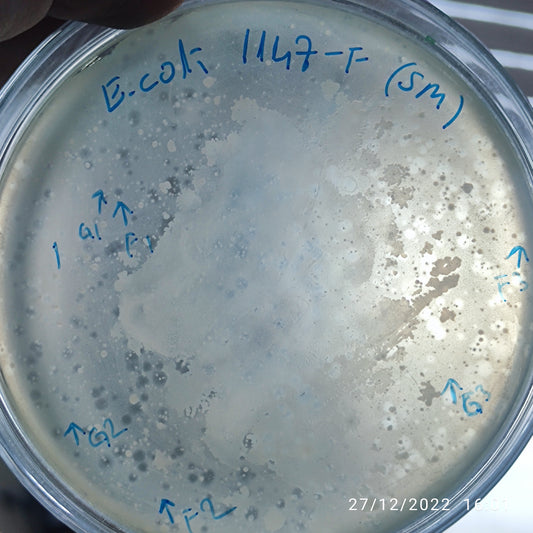
Escherichia coli bacteriophage 101147G
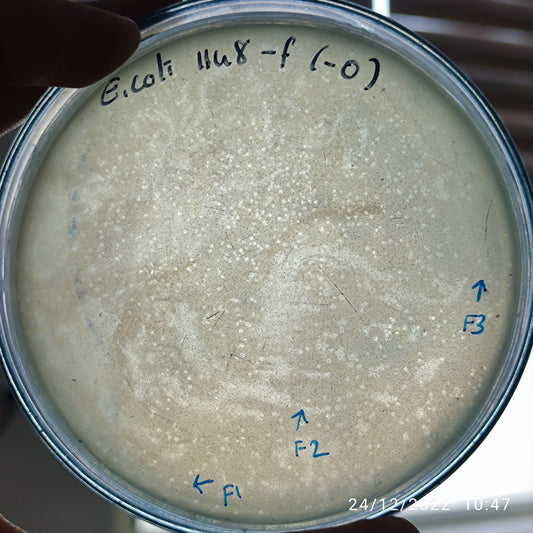
Escherichia coli bacteriophage 101148F

-
Escherichia coli bacteriophage 101131F
Regular price $500.00 USDRegular priceUnit price per -
Escherichia coli bacteriophage 101133F
Regular price $500.00 USDRegular priceUnit price per -
Escherichia coli bacteriophage 101133G
Regular price $500.00 USDRegular priceUnit price per -
Escherichia coli bacteriophage 101135F
Regular price $400.00 USDRegular priceUnit price per -
Escherichia coli bacteriophage 101138F
Regular price $500.00 USDRegular priceUnit price per -
Escherichia coli bacteriophage 101139F
Regular price $500.00 USDRegular priceUnit price per -
Escherichia coli bacteriophage 101140F
Regular price $500.00 USDRegular priceUnit price per -
Escherichia coli bacteriophage 101142F
Regular price $500.00 USDRegular priceUnit price per -
Escherichia coli bacteriophage 101143F
Regular price $500.00 USDRegular priceUnit price per -
Escherichia coli bacteriophage 101143G
Regular price $500.00 USDRegular priceUnit price per -
Escherichia coli bacteriophage 101144F
Regular price $500.00 USDRegular priceUnit price per -
Escherichia coli bacteriophage 101147F
Regular price $500.00 USDRegular priceUnit price per -
Escherichia coli bacteriophage 101147G
Regular price $500.00 USDRegular priceUnit price per -
Escherichia coli bacteriophage 101148F
Regular price $500.00 USDRegular priceUnit price per -
Escherichia coli bacteriophage 101149F
Regular price $500.00 USDRegular priceUnit price per -
Escherichia coli bacteriophage 101149G
Regular price $500.00 USDRegular priceUnit price per